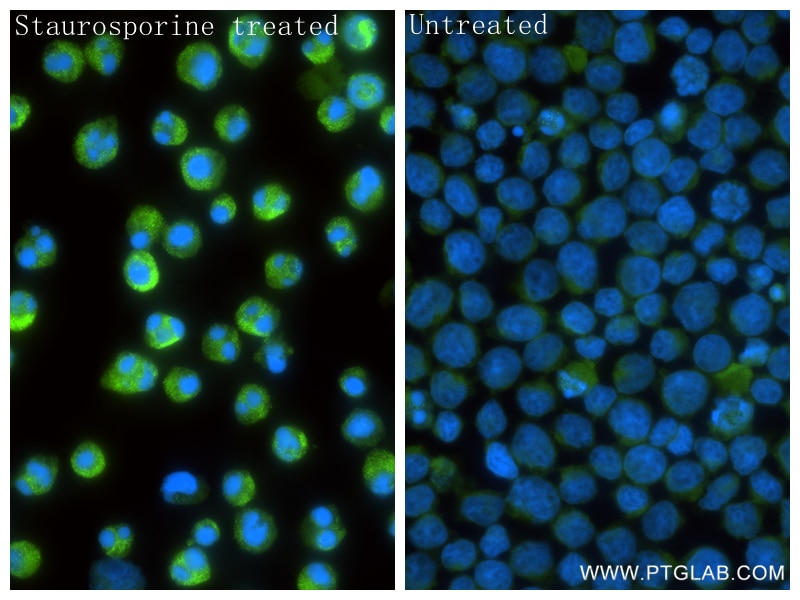
Immunofluorescence (IF) / fluorescent staining of Jurkat cells using Cleaved PARP1 (Asp214) Recombinant monoclonal anti (85175-5-RR)

Tested Applications
| Positive WB detected in | Staurosporine treated HeLa cells, Staurosporine treated Jurkat cells |
| Positive IF/ICC detected in | Staurosporine treated Jurkat cells |
Recommended dilution
| Application | Dilution |
|---|---|
| Western Blot (WB) | WB : 1:5000-1:50000 |
| Immunofluorescence (IF)/ICC | IF/ICC : 1:400-1:1600 |
| It is recommended that this reagent should be titrated in each testing system to obtain optimal results. | |
| Sample-dependent, Check data in validation data gallery. | |
Product Information
85175-5-RR targets Cleaved PARP1 (Asp214) in WB, IF/ICC, ELISA applications and shows reactivity with human samples.
| Tested Reactivity | human |
| Host / Isotype | Rabbit / IgG |
| Class | Recombinant |
| Type | Antibody |
| Immunogen |
Peptide Predict reactive species |
| Full Name | poly (ADP-ribose) polymerase 1 |
| Calculated Molecular Weight | 1014 aa, 113 kDa |
| Observed Molecular Weight | 89 kDa |
| GenBank Accession Number | BC037545 |
| Gene Symbol | PARP1 |
| Gene ID (NCBI) | 142 |
| RRID | AB_3744077 |
| Conjugate | Unconjugated |
| Form | Liquid |
| Purification Method | Protein A purification |
| UNIPROT ID | P09874 |
| Storage Buffer | PBS with 0.02% sodium azide and 50% glycerol, pH 7.3. |
| Storage Conditions | Store at -20°C. Stable for one year after shipment. Aliquoting is unnecessary for -20oC storage. 20ul sizes contain 0.1% BSA. |
Background Information
PARP1 (poly(ADP-ribose) polymerase 1) is a nuclear enzyme catalyzing the poly(ADP-ribosyl)ation of many key proteins in vivo. The normal function of PARP1 is the routine repair of DNA damage. Activated by DNA strand breaks, the PARP1 is cleaved into an 85 to 89-kDa COOH-terminal fragment and a 24 kDa NH2-terminal peptide by caspases during the apoptotic process. The appearance of PARP fragments is commonly considered an important biomarker of apoptosis. In addition to caspases, other proteases like calpains, cathepsins, granzymes, and matrix metalloproteinases (MMPs) have also been reported to cleave PARP1 and give rise to fragments ranging from 42-89 kDa.
This antibody only recognizes the cleaved form of PAPR1 but not full-length PARP1.
Protocols
| Product Specific Protocols | |
|---|---|
| IF protocol for Cleaved PARP1 (Asp214) antibody 85175-5-RR | Download protocol |
| WB protocol for Cleaved PARP1 (Asp214) antibody 85175-5-RR | Download protocol |
| Standard Protocols | |
|---|---|
| Click here to view our Standard Protocols |